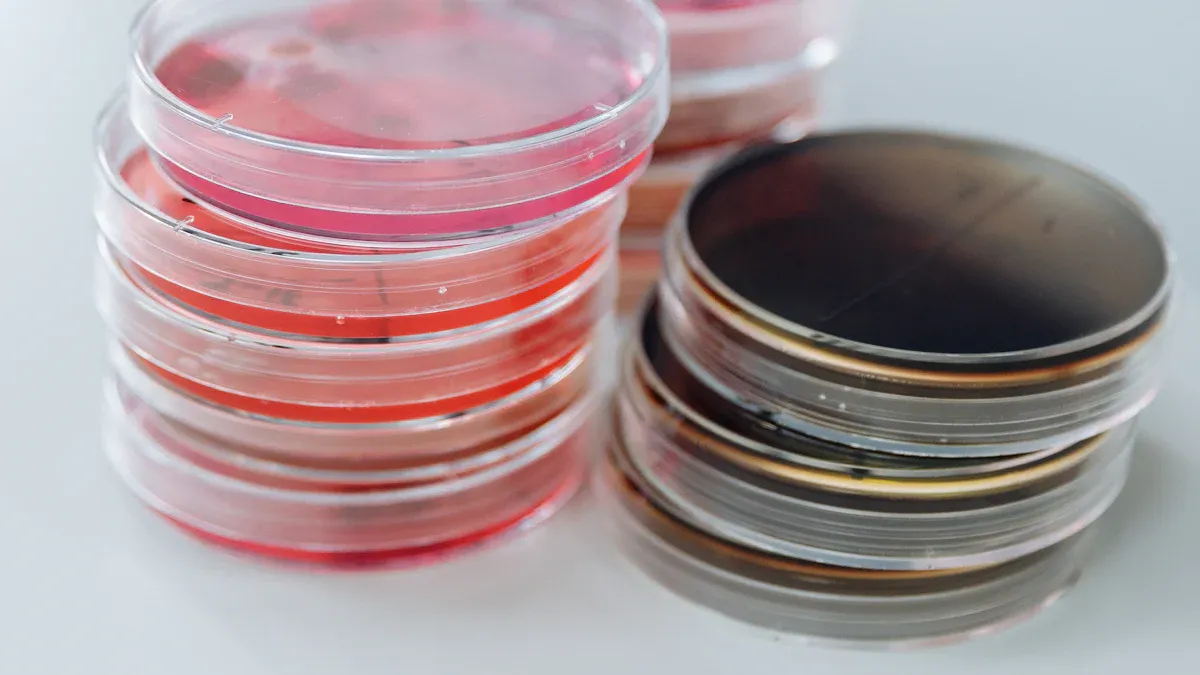
Fish

Never ignore these fish gelatin powder pros and cons
Fish gelatin powder has gained traction due to consumer interest in health-conscious and sustainable products. The global market expects to reach $0.44 billion in 2026, reflecting a 6.3% growth rate. People value allergen-friendly, nutritious options, but concerns about taste, price, and ethics remain significant.
Fish Gelatin Powder Pros in 2026

Allergen-Friendly and Dietary Suitability
Many consumers seek alternatives to mammalian gelatin due to allergy risks. Fish gelatin powder offers a solution for those with sensitivities to bovine or porcine gelatin.
- Fish-based gelatins can serve as alternatives for individuals with mammalian gelatin allergies, indicating a potential for reduced allergic reactions.
Dietary preferences and religious practices also influence ingredient choices. Fish gelatin appeals to Muslims and Jews who avoid pork and beef products. Pescatarians and some vegetarians find it suitable, as it aligns with their dietary restrictions and provides a marine-based alternative.
Functional Benefits: Texture, Gelling Power, Versatility
Manufacturers value fish gelatin powder for its unique functional properties. It acts as a gelling, thickening, and stabilizing agent in foods such as dairy, bakery, and meat products. The pharmaceutical industry also uses it for encapsulation and active packaging, benefiting from its superior gas barrier and mechanical properties.
A comparison of gelling strength highlights its performance:
| Gelatin Type | Melting Enthalpy (∆HM) | Melting Temperature (°C) |
|---|---|---|
| Bovine Gelatin | 124.2 J g−1 | 108 |
| Porcine Gelatin | 169.8 J g−1 | 110 |
| Fish Gelatin | 266.7 J g−1 | 118 |
Fish gelatin contains a higher proportion of free α-type chains, resulting in reduced viscosity. Manufacturers often use a higher concentration to achieve the desired gelling effect. Despite this, its versatility in various applications remains a significant advantage.
Sustainability and Sourcing
Sustainability drives many purchasing decisions in 2026. Fish gelatin powder is primarily sourced from byproducts such as fish skin and bones. This practice reduces waste and adds economic value to the fish processing industry.
- Utilizing these byproducts promotes environmental sustainability by minimizing waste and enhancing resource efficiency.
Fish gelatin production often results in a lower carbon footprint and reduced water usage compared to bovine and porcine gelatin. Life-cycle assessments support its reputation as a more sustainable alternative, making it attractive to environmentally conscious consumers.
Health and Nutritional Advantages
Fish gelatin powder provides a high-quality protein source with a beneficial amino acid profile. The following table summarizes its nutritional components:
| Nutritional Component | Value/Description |
|---|---|
| Protein Content | 89.1% (Jongjareonrak et al., 2010) |
| Predominant Amino Acids | Glycine (359 residues/1000) from giant catfish, Proline (288 residues/1000) from tuna fin |
| Other Amino Acids | High proline and hydroxyproline in giant catfish |
- Rich source of glycine, which supports nail and hair growth.
- May help reduce symptoms associated with arthritis.
- Free of cholesterol and sugar, and low in fat.
Clinical studies have shown health benefits from gelatin supplementation. One study on osteoarthritis patients reported significant improvements in pain and physical activities with a daily intake of 2g gelatin over 70 days. Another study involving athletes found improvements in joint pain, mobility, and inflammation with 10g collagen daily for 24 weeks.
Tip: Individuals seeking to boost protein intake or support joint health may benefit from incorporating fish gelatin powder into their diet.
Fish Gelatin Powder Cons in 2026
Flavor and Odor Concerns
Many consumers notice that fish gelatin powder can impart a distinct flavor and odor to foods. This characteristic often limits its use in delicate recipes or products where a neutral taste is essential. The fishy aroma results from volatile compounds, including aldehydes, ketones, and alcohols, which remain after processing. Manufacturers have developed several methods to reduce these sensory drawbacks:
- Cleaning the outer surface of swimming bladders with water.
- Rubbing swimming bladders with coarse salt and soaking them in salt water to remove the fishy smell.
- Vacuum freeze drying the cleaned bladders to obtain a gelatin liquid.
Gelatin from skin pretreated with citric acid had lower fishy odor and flavor than that from skin pretreated using acetic acid. The lower fishy odor and flavor, with coincidentally lower abundance of volatile compounds, was found in gelatin obtained by spray drying, in comparison with its freeze-dried counterpart. Thus, spray drying in conjunction with an appropriate pretreatment could be an effective method for production of gelatin with negligible undesirable fishy odor and flavor.
Despite these advances, some residual taste and smell may persist, especially in sensitive applications.
Cost and Availability
Fish gelatin powder often costs more than bovine or porcine gelatin. Several factors contribute to this higher price:
- Limited supply and specialized processing requirements.
- Certification requirements, such as halal or kosher, add to the cost.
- Lower gel strength and heat sensitivity require advanced stabilization techniques.
- Sourcing options remain limited, which drives prices higher.
- Production costs generally exceed those of standard bovine gelatin.
These factors also affect availability. Not every supplier can provide consistent quality or certification, which complicates procurement for food and pharmaceutical companies.
Religious and Ethical Considerations
Religious dietary laws play a significant role in the acceptance of fish gelatin powder. The following table summarizes its status under different conditions:
| Condition | Acceptance Status |
|---|---|
| Fish gelatin with reliable Kosher certification | Accepted as Halal |
| Not mixed with non-Halal materials | Permissible |
| Fish species accepted as edible | Depends on specific school nuances |
Some religious authorities accept fish gelatin if it meets strict sourcing and processing criteria. Others require additional verification, especially regarding the species used and the absence of cross-contamination.
Ethical concerns also arise. Animal welfare organizations highlight that gelatin production involves using animal parts from slaughterhouses, where animals are killed specifically for their skins and bones. This raises questions about animal treatment and the conditions under which they are kept and processed. Environmental groups point out that processing plants can contribute to pollution and unpleasant odors, affecting nearby communities.
Performance Differences vs. Other Gelatins
Fish gelatin powder does not always match the performance of bovine or porcine gelatin in culinary and industrial applications. Controlled experiments reveal several differences:
- Fish gelatin from catfish skin and bone has melting and setting temperatures that are significantly lower than those of commercial gelatin.
- Skin gelatin exhibits higher water holding and fat binding capacities compared to bone gelatin.
- The foaming capacity and foam stability of skin gelatin surpass those of bone gelatin, indicating its potential as a superior source of edible gelatin.
However, limitations remain. The table below compares key properties:
| Property | Fish Gelatin | Bovine Gelatin | Porcine Gelatin |
|---|---|---|---|
| Solubility | Poor at high temperatures | Good, easily dissolved in hot water | Good, easily dissolved in hot water |
| Flavor Characteristics | Slight fishy flavor | Mild, slight meaty flavor | Neutral, little flavor impact |
| Gel Strength | Weaker, softer texture | Strong, firm texture | Strong, elastic texture |
| Melting Properties | Lower melting point, quick dissolve | Higher melting point, stable dissolve | Higher melting point, stable dissolve |
| Shelf Life Stability | Poor, affected by humidity | Good, stable under proper conditions | Good, stable under proper conditions |
These differences mean that fish gelatin powder may not suit every recipe or industrial process. Manufacturers must adjust formulations or processing methods to achieve the desired results.
Practical Considerations for Fish Gelatin Powder in 2026
Best Uses and Applications
Chefs and manufacturers select fish gelatin powder for its unique gelling and stabilizing properties. It works well in a variety of recipes, especially those that require a delicate texture or clear finish. Popular applications include:
- Marshmallows with a melt-in-the-mouth texture
- Fondant and translucent candies
- Yoghurt and ice cream for improved mouthfeel
- Sauces and savory dishes
The following table highlights leading products and their uses:
| Product Name | Description |
|---|---|
| Louis Francois Fish Gelatin Powder | Premium-quality gelatin for desserts, confections, and savory dishes. |
| Cuisine Tech Fish Gelatin Powder 225 Bloom | High-strength gelatin for professional mousses and panna cotta. |
Who Should Use Fish Gelatin Powder
Fish gelatin powder serves as a suitable alternative for individuals with allergies to mammalian gelatin. People with alpha-gal syndrome (AGS) often react to bovine or porcine gelatin, so they benefit from this marine-based option. Diets that exclude pork or beef for religious reasons, such as Jewish, Muslim, or Hindu dietary laws, may also allow fish gelatin. Health professionals recommend checking labels for gelatin content in foods, medications, and personal care products.
Tip: Those seeking a protein boost or improved joint health may consider adding fish gelatin powder to their diet.
Who Should Avoid Fish Gelatin Powder
Some individuals experience adverse reactions to gelatin-containing products. Documented cases include IgE-mediated anaphylactic reactions, especially with certain vaccines. People with known fish allergies should avoid fish gelatin powder. The table below outlines dietary restrictions:
| Dietary Group | Restrictions |
|---|---|
| Muslims | No porcine products allowed |
| Jews | No porcine products allowed |
| Hindus | No bovine products allowed |
Those with severe allergies or specific dietary needs should consult a healthcare provider before use.
Fish gelatin powder presents distinct advantages and drawbacks for consumers. They should evaluate sourcing practices, production methods, and certifications. Nutritionists highlight its high protein content and amino acid profile. Market growth reflects rising demand for alternative proteins. Common misconceptions persist, but experts confirm its value as a pure protein source.
FAQ
What makes fish gelatin powder different from bovine or porcine gelatin?
Fish gelatin powder comes from marine sources. It offers a unique amino acid profile, lower melting point, and often suits those with mammalian allergies.
Can people with fish allergies use fish gelatin powder safely?
People with fish allergies should avoid fish gelatin powder. Even trace amounts can trigger allergic reactions. Always consult a healthcare professional before use.
Does fish gelatin powder affect the taste of recipes?
Some users report a mild fishy flavor or odor. Manufacturers use advanced processing to minimize this, but sensitive recipes may still show subtle taste differences.
See Also
Comparing Bovine Gelatin Powder With Fish And Pork Varieties
Key Indicators Of High-Quality Bovine Gelatin Powder To Recognize
10 Creative Methods To Incorporate Bovine Gelatin Powder In Cooking
Reasons Bovine Gelatin Powder Is An Effective Health Booster